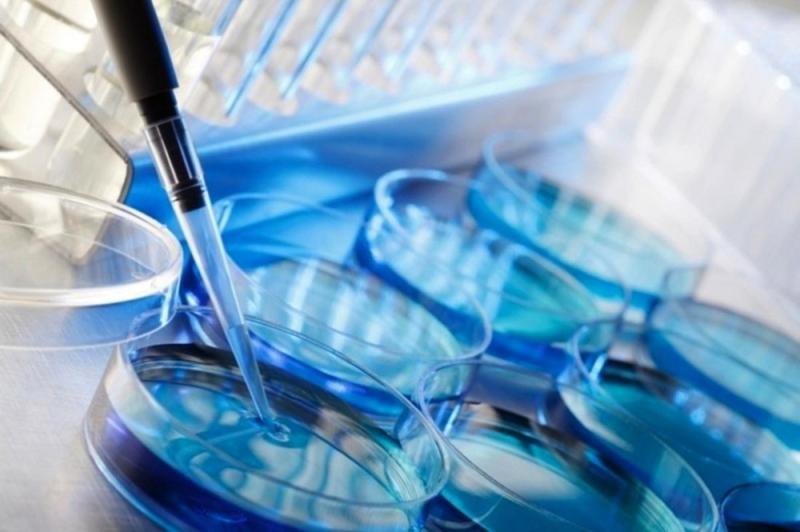

Press release
Global IVF Devices and Consumables Market is Likely to Tread Growth Parameters in a Swift Manner Till 2030
The Latest Report, titled 'IVF Devices and Consumables Market' Global Industry Trends, Share, Size, Growth, Opportunity and Forecast 2023-2030, by Global Market Vision offers a comprehensive analysis of the industry, which comprises insights on the IVF Devices and Consumables market analysis. The report also includes competitor and regional analysis, and contemporary advancements in the global market.The IVF Devices and Consumables market has been growing significantly in recent years, driven by a number of key factors, such as increasing demand for its products, expanding customer base, and technological advancements. This report provides a comprehensive analysis of the IVF Devices and Consumables market, including market size, trends, drivers and constraints, Competitive Aspects, and prospects for future growth.
The purpose of the market research study with the aim of gaining a comprehensive understanding of the IVF Devices and Consumables industry. The study will investigate the industry's economic potential and provide a detailed analysis of its past, present, and future prospects. The ultimate goal is to equip the client with the necessary knowledge to make informed decisions regarding resource allocation and investment. The report is 110+ pages in length and includes a detailed table of contents, as well as figures, tables, and charts that provide valuable insights into the industry.
Get PDF Sample Report + All Related Tables and Graphs
at: https://globalmarketvision.com/sample_request/17976
Our Sample Report Includes:
• Updated Report Introduction, Overview, and In-depth Industry Analysis for 2030.
• 110+ page research report (including new research).
• Provide Requests guidelines by chapter.
• 2023 Regional Analysis Revised with Graphical Representation of Size, Share, and Trends
• Contains an updated list of tables and figures.
• The report has been updated to include the top market players business strategies, sales volume, and revenue analysis.
Major Market Players Profiled in the Report include:
Bio-Rad, Lee Biosolutions, Abcam, Prospec-Tany Technogene Ltd, Tosoh, Fosun Pharmaceutical, Wuhan Huamei Biotech Co
This global IVF Devices and Consumables market study is essential for buyers because it offers a thorough analysis of the market, taking into account current trends, growth factors, barriers, and opportunities. The report's insights into the market's competitive landscape and major players can be used by buyers to make knowledgeable business decisions and reMail one step ahead of the competition.
The report also offers a thorough analysis of the market's Mail segments in accordance with type, application, and location to aid clients in identifying profitable investment opportunities. The market trends, drivers, opportunities, and challenges that are most likely to have an impact on the market's trajectory of development over the course of the forecast period are all fully examined in the report. Buyers can use this knowledge to create practical strategies that help them take advantage of new opportunities and get past challenges.
IVF Devices and Consumables Market by Type:
Fresh Embryo IVF
Frozen Embryo IVF
Donor Egg IVF
IVF Devices and Consumables Market by Application:
Instrument
Sperm Separation System
Cryosystem
Incubator
Imaging System
Ovum Aspiration Pump
Cabinet
Micromanipulator
Others
IVF Devices and Consumables Market Segment by Region:
• North America (United States, Canada and Mexico)
• Europe (Germany, France, United Kingdom, Russia, Italy, and Rest of Europe)
• Asia-Pacific (China, Japan, Korea, India, Southeast Asia, and Australia)
• South America (Brazil, Argentina, Colombia, and Rest of South America)
• Middle East & Africa (Saudi Arabia, UAE, Egypt, South Africa, and Rest of Middle East & Africa)
Research Objectives:
• Focuses on the key manufacturers, to define, pronounce and examine the value, sales volume, market share, market competition landscape, SWOT analysis, and development plans in the next few years.
• To share comprehensive information about the key factors influencing the growth of the market (opportunities, drivers, growth potential, industry-specific challenges and risks).
• To analyze the with respect to individual future prospects, growth trends and their involvement to the total market.
• To analyze reasonable developments such as agreements, expansions new product launches, and acquisitions in the market.
• To deliberately profile the key players and systematically examine their growth strategies.
Scope of IVF Devices and Consumables Market:
The IVF Devices and Consumables market analysis utilizes market dynamics and growth drivers to project the growth rate and market worth. The study is informed by up-to-date industry developments, opportunities, and trends, providing a comprehensive understanding of the market. The report includes a thorough analysis of the market and vendor landscape, along with a SWOT analysis of the leading vendors.
Report Coverage:
This report offers comprehensive coverage of the market, providing detailed insights and statistical data on the latest trends and business strategies implemented by key players in the industry. Additionally, it analyzes recent advancements in the field and significant industry developments. With a clear understanding of market drivers and restraints, businesses can make informed decisions and develop effective strategies for growth and success.
Furthermore, the report goes beyond just highlighting the current state of the market and explores potential future trends, helping businesses to prepare for future developments and stay ahead of the competition. With a wealth of information and expert analysis, this report is an essential resource for anyone looking to gain insights into the industry and make informed business decisions.
Revenue and Sales Estimation:
The report utilizes historical revenue and sales volume data, as well as top-down and bottom-up approaches, to forecast the complete market size and estimate forecast numbers for key regions. Additionally, the report includes classifications for recognized types and end-use industries. This triangulation of data provides a comprehensive and accurate analysis.
Pricing Analysis:
The evaluation of pricing is crucial in shaping consumers' purchasing decisions. Conducting a price analysis enables businesses to compare their prices with those of competitors and substitute products. The IVF Devices and Consumables Market market is a research-intensive sector with a strong focus on product analysis and high investment in research and development. This emphasis on innovation is expected to drive growth during the forecast period of 2023-2030.
Purchasing the IVF Devices and Consumables Market Report for the Following Reasons:
⮞The study examines emerging market trends as well as the likelihood that various trends will impact expansion.
⮞The analysis also discusses the factors, challenges, and opportunities that will have a significant impact on the global IVF Devices and Consumables industry.
⮞Technological tools and benchmarks that reflect the industry's projected growth of the IVF Devices and Consumables industry.
⮞The research includes a detailed analysis of market statistics as well as historical and current growth conditions in order to provide futuristic growth estimates.
⮞The research paper also analyze the market size in the past and present.
⮞The charts show the year-over-year growth (percent) and compound annual growth rate (CAGR) for the given projected period based on a variety of metrics.
⮞The research contains a market overview, geographical breadth, segmentation, and financial performance of main competitors.
⮞The study examines the future growth rate, market size, and market worth.
Direct Purchase this Market Research Report Now @ https://globalmarketvision.com/checkout/?currency=USD&type=single_user_license&report_id=17976
Get in Touch with Us
Sarah Ivans | Business Development
Phone: +1 617 297 8902
Email: sales@globalmarketvision.com
Global Market Vision
Website: www.globalmarketvision.com
About Global Market Vision
Global Market Vision consists of an ambitious team of young, experienced people who focus on the details and provide the information as per customer's needs. Information is vital in the business world, and we specialize in disseminating it. Our experts not only have in-depth expertise, but can also create a comprehensive report to help you develop your own business.
With our reports, you can make important tactical business decisions with the certainty that they are based on accurate and well-founded information. Our experts can dispel any concerns or doubts about our accuracy and help you differentiate between reliable and less reliable reports, reducing the risk of making decisions. We can make your decision-making process more precise and increase the probability of success of your goals.
This release was published on openPR.
Permanent link to this press release:
Copy
Please set a link in the press area of your homepage to this press release on openPR. openPR disclaims liability for any content contained in this release.
You can edit or delete your press release Global IVF Devices and Consumables Market is Likely to Tread Growth Parameters in a Swift Manner Till 2030 here
News-ID: 3093180 • Views: …
More Releases from Global Market Vision
Rapid Growth in Solar Pump Market Driven by Clean Energy Demand and Government I …
[Pune, India] - [10/07/2025] - [Global Market Vision], a leading provider of market intelligence, has released its latest report on the Solar Pump Market, projecting significant growth driven by rising demand for renewable energy solutions, increasing agricultural modernization, and supportive government policies worldwide.
According to the GMV, the global solar pump market is expected to grow at a CAGR of 33%, reaching INR 60 billion by 2024. This growth is fueled…
5G in Healthcare: The Next Frontier for Innovation and Patient Care
Market Overview:
The fundamental components of healthcare could all be changed and enhanced by 5G networks. Over the past several years, the use of 5G networks in healthcare has increased, and their applications have been strengthened by advancements in robotics, IoT, and AI that will change healthcare systems into a new connected ecosystem. The main challenge faced by healthcare systems is the fastest transmission of data.
5G technology is revolutionizing the healthcare…
Dual Screen Laptops Market Size, Share, Trends, Growth Report and Forecast
The global dual-screen laptops market is witnessing steady growth, with a forecasted increase from $2.59 billion in 2023 to $3.26 billion by 2028, driven by a compound annual growth rate (CAGR) of about 5.0%. This growth is fueled by advancements in display technology, the rising demand for portable devices, and the growing popularity of dual-screen laptops among gamers, content creators, and professionals who benefit from the enhanced multitasking capabilities these…
Active & Intelligent Packaging Market Market Data and In-depth Analysis to 2032 …
Future Market Consulting Global Market Vision has published a research report on the "Global Active & Intelligent Packaging Market", which provides a comprehensive outline of the factors responsible for the market growth from 2018 to 2032. The Active & Intelligent Packaging Market value is USD XX million in 2023 and is expected to grow to USD XX million by 2032 with a CAGR of XX% during the forecast period. …
More Releases for IVF
IVF Services Market Set for Explosive Growth | Nova IVF, Boston IVF, Monash IVF
HTF MI recently introduced Global IVF Services Market study with 143+ pages in-depth overview, describing about the Product / Industry Scope and elaborates market outlook and status (2024-2032). The market Study is segmented by key regions which is accelerating the marketization. At present, the market is developing its presence. Some key players from the complete study are Virtus Health, Monash IVF, Care Fertility, Apollo Hospitals, Boston IVF, CooperSurgical, Genea Biomedx,…
IVF Services Market Moving in the Right Direction: Bangkok IVF center, Fertility …
According to HTF Market Intelligence, the Global IVF Services market to witness a CAGR of 0.098% during the forecast period (2023-2029). The Latest Released IVF Services Market Research assesses the future growth potential of the IVF Services market and provides information and useful statistics on market structure and size.
This report aims to provide market intelligence and strategic insights to help decision-makers make sound investment decisions and identify potential gaps and…
IVF Devices and Consumables Market Size To Reach USD 7.73 Billion, Globally, By …
In vitro fertilization (IVF) is a type of assisted reproductive technology in which the ovum is artificially fertilized in laboratory settings and then implanted into the uterus. IVF is one of the widely used treatments, which assists couples with infertility problems, single mothers, and the LGBT community to procreate. Increase in infertility rate, rise in awareness toward IVF, growth in demand for advanced IVF technologies, and surge in IVF success…
IVF Services Market size is Generating Revenue of $25.6 Billion by 2026 | Fresh …
In vitro fertilization (IVF) is a type of assisted reproductive technology in which the ovum is artificially fertilized in laboratory settings and then implanted into the uterus. IVF is one of the widely used treatments, which assists couples with infertility problems and single mothers & the LGBT community to procreate. Increase in infertility rate, rise in trend of delayed pregnancies, surge in IVF success rate, and upsurge in disposable income…
Growth Dynamics on In Vitro Fertilization Market 2020-2026| Key Players: Monash …
The global in vitro fertilization (IVF) market size is prophesized to reach USD 36.39 billion by 2026, with a CAGR 10.1% by 2026. This is attributable to the increasing cases of infertility among people worldwide. This is more common in males than female partners. The market value was USD 16.89 billion in 2018. IVF is a fertilization process wherein sperm and eggs are retrieved as a sample and are combined…
How In Vitro Fertilization Market Will Dominate In Coming Years? Key Players: Mo …
The global in vitro fertilization (IVF) market size is prophesized to reach USD 36.39 billion by 2026, with a CAGR 10.1% by 2026. This is attributable to the increasing cases of infertility among people worldwide. This is more common in males than female partners. The market value was USD 16.89 billion in 2018. IVF is a fertilization process wherein sperm and eggs are retrieved as a sample and are combined…